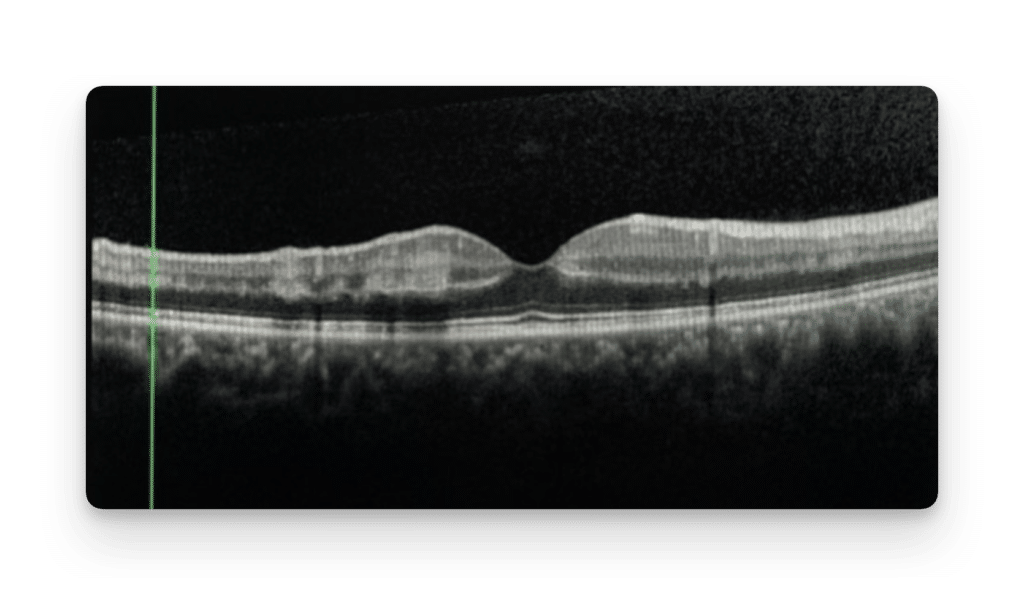

¹Illinois Eye and Ear Infirmary, Department of Ophthalmology and Visual Sciences, University of Illinois at Chicago, Chicago, IL ²University of Calgary, Section of Ophthalmology, Department of Surgery, Calgary, Alberta, Canada.
Supported by an unrestricted grant from Research to Prevent Blindness and by NIH Core Grant EY01792.

A 16-year-old man was referred with a two-week history of multiple, small scotomas in his right eye (OD). Upon presentation, visual acuities (VA) were 20/25 OD and 20/20 left eye (OS). Intraocular pressures were 18 mmHg OD and 17 mmHg OS. Anterior segment examination was normal in both eyes (OU). Ophthalmoscopy and ultra-wide field photography revealed multiple, dark, geographic-shaped retinal discolorations scattered along the retinal arterioles OD (Figure 1). The referring physician letter noted venous dilation, venous tortuosity, and mild disc edema that had been present two weeks earlier in the right eye, consistent with an impending central retinal vein occlusion (CRVO). These retinal findings were no longer present when the patient presented for his retina consultation visit.
Optical coherence tomography (OCT) scans of the macula showed hyperreflective bands at the level of the inner nuclear layer consistent with paracentral acute middle maculopathy (PAMM) lesions (Figure 2). OCT scans corresponding to the dark, geographic retinal lesions showed outer retinal attenuation with hyporeflective changes at the ellipsoid zone (Figure 3). No retinal vascular occlusions or delayed circulation times were detected on wide-field fluorescein angiography (FA). Observation was recommended.
Two months later, the patient reported resolution of his scotomas. VA had improved to 20/20 OD and remained 20/20 OS. Repeat ophthalmoscopy showed peripheral arteriolar attenuation with multiple areas of retinal darkening, along the retinal vessels, which were similar in shape and size to initial presentation. OCT through these areas of retinal darkening demonstrated persistent hyporeflective changes at the ellipsoid zone, indicative of dark without pressure (DWP) lesions. Ten months after presentation, fundus examination showed decrease in size of the DWP lesions. Visual acuities remained 20/20 OU without symptoms. This patient was diagnosed with dark without pressure fundus lesions OD with concurrent PAMM lesions, in the setting of an impending CRVO. The impending CRVO was postulated to result from dehydration combined with high caffeine intake.
The etiology of DWP remains unclear. Some theories regarding the OCT appearance include abnormal reflectivity of the internal limiting membrane, retinal pigment epithelium or abnormal photoreceptor structure.1-2 The normal hyperreflective ellipsoid zone seen with OCT imaging is theorized to be due to a high density of mitochondria.3 It is plausible that metabolic changes within photoreceptors can result in loss of mitochondria and alteration of the optical parameters in the retina and manifest as DWP. Another theory suggests that hypo-reflective findings in the outer retina may be secondary to photopigment within DWP lesions and which more effectively absorbs short-wavelength light compared to the rest of the fundus.2
Multimodal imaging can differentiate DWP from similar appearing lesions, such as the foveal depression sign. The foveal depression sign indicates prior retinal infarction and manifests as OCT retinal thinning, whereas the DWP lesions are characterized by hyporeflective changes of the ellipsoid zone.
References
1Nagpal KC, Goldberg MF, Asdourian G, et al. Dark-without-pressure fundus lesions. Brit. J. Ophthalmol. 1975; 59 (9): 476-9.
2Fawzi AA, Nielsen JS, Mateo-Montoya A, et al. Multimodal imaging of white and dark without pressure fundus lesions. Retina. 2014; 34 (12): 2376-87.
3Steptoe PJ, Beare NAV, Semple MG. Comment on: Dark without pressure retinal changes in a paediatric age group. Eye. 2021; 35: 3163-4.
Figure Legends